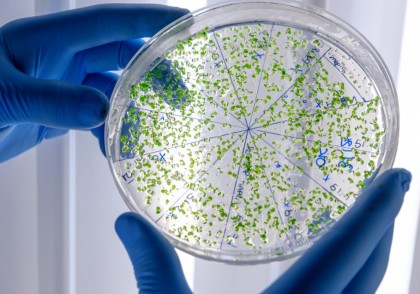
Deficiența de zinc poate vulnerabiliza bacteriile rezistente la antibiotice

Deficiența de zinc poate vulnerabiliza bacteriile rezistente la antibiotice
Cercetătorii de la Universitatea McMaster au descoperit o vulnerabilitate critică a bacteriilor rezistente la antibiotice: deficitul de zinc. Studiul, publicat în Nature Microbiology, arată că zincul joacă un rol esențial în rezistența anumitor bacterii la antibiotice. Prin limitarea disponibilității zincului, bacteriile devin mai susceptibile la tratamente antibiotice, inclusiv la medicamente pe care le rezistau anterior.
Context
Rezistența la antibiotice este o problemă majoră de sănătate publică, amenințând eficacitatea unor antibiotice de ultimă instanță, precum carbapenemele. Aceste medicamente sunt folosite atunci când alte opțiuni eșuează, însă rezistența bacteriană, facilitată de gene precum cele care codifică metalo-β-lactamaze, compromite eficiența lor.
„Carbapenemele sunt esențiale în clinică, dar eficacitatea lor este în pericol din cauza rezistenței bacteriene,” explică Megan Tu, doctorandă și prima autoare a studiului.
Descoperiri
-
Impactul deficitului de zinc asupra bacteriilor rezistente
- În condiții de deficit de zinc, bacteriile Klebsiella pneumoniae și Pseudomonas aeruginosa, cunoscute pentru rezistența lor la carbapeneme, au suferit un „cost de fitness” metabolic.
- Aceste bacterii au fost forțate să renunțe la unele mecanisme de apărare pentru a menține rezistența la carbapeneme.
-
Exploatarea vulnerabilităților
- Bacteriile rezistente la carbapeneme au devenit susceptibile la azitromicină, un antibiotic comun, deși, în mod tradițional, azitromicina nu este eficientă împotriva bacteriilor gram-negative, cum sunt K. pneumoniae și P. aeruginosa.
-
Abordarea prin stres nutrițional
- Limitarea zincului a expus bacteriile la tratamente eficiente cu azitromicină, demonstrând potențialul de a reutiliza medicamente vechi pentru infecții rezistente la antibiotice.
Implicații terapeutice
Această descoperire are implicații semnificative pentru tratarea infecțiilor rezistente la antibiotice:
- Strategii bazate pe deficiența de nutrienți: Limitarea disponibilității zincului ar putea deveni o abordare complementară pentru tratamentele existente.
- Reutilizarea medicamentelor existente: Studiul deschide noi perspective pentru utilizarea azitromicinei în tratarea infecțiilor bacteriene rezistente la carbapeneme.
- Extinderea aplicațiilor clinice: Studiul demonstrează o nouă utilitate clinică a azitromicinei împotriva bacteriilor gram-negative, până acum neafectate de acest antibiotic.
Concluzii
Acest studiu reprezintă un pas important în combaterea rezistenței la antibiotice. Identificarea vulnerabilităților bacteriene în condiții de stres nutrițional ar putea ghida dezvoltarea unor terapii noi sau reutilizarea unor medicamente existente. După cum afirmă Eric Brown, autor principal al studiului, „poți trata anumite infecții rezistente cu azitromicină.”
Exploiting the fitness cost of metallo-β-lactamase expression can overcome antibiotic resistance in bacterial pathogens.
Nature Microbiology.
doi.org/10.1038/s41564-024-01883-8.
Image by wirestock on Freepik
Copyright ROmedic: Articolul se află sub protecția drepturilor de autor. Reproducerea, chiar și parțială, este interzisă!
- Tramadolul în tratamentul durerii cronice: beneficii minore, riscuri semnificative [meta-analiză]
- Sistem inovator de eliberare a estradiolului pentru tratamentul osteoporozei în postmenopauză
- Oamenii de știință transformă drojdia de bere în mini-fabrici pentru medicamente inteligente
- Analgezicele comune favorizează rezistența antimicrobiană la Escherichia coli
intră pe forum